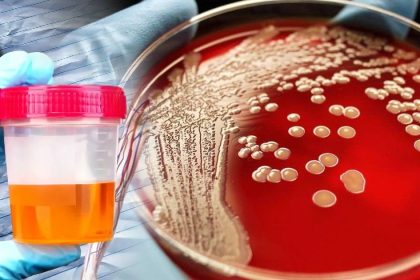
Böbreklerinizde Sorun Olduğunu Gösteren 8 Önemli Belirti 18 böbreklerde sorun olduğunun belirtileri

Uyumadan Önce Ayaklarınıza Yapın, Bütün Yorgunluğunuzu Atın
Masaj, antik dönemlerde şifa sağlayan sanatlarından biriydi. Evet, masaj binlerce yıldır uygulanmaktadır.…
Ayaklarınızı Alüminyum Folyo ile Sarın ve 1 Saat Bekletin Faydası Sizi Çok Şaşırtacak!
Bayanlar ve baylar, evlerinizde alüminyum folyo olduğunu biliyorum! Gerçekten kendinize sormalısınız. Neden…
Bir Ayda Yaklaşık 6 Kilo Vermenizi Sağlayacak Diyet Tarifi
Kilo vermenizi sağlayacak birçok diyet vardır. Fakat bu diyetlerin yalnızca bir kısmı…
Çinlilerin Genç Kalmak İçin Kullandığı 6 Mucize Yağ
Yaşlanmayı hiçbirimiz istemeyiz değil mi? Günümüzde çoğunlukla kozmetik sektöründe satılan yaşlanma belirtilerini…
İki Malzemeli Bu Tarif Yüzünüzdeki Lekeleri 3 Gecede Geçiriyor
Hanımlar, bu yazıya başlamadan önce, size basit bir soru sormak istiyorum -…
Kadınlarda Kalp Krizi 1 Ay Öncesinden Kendini Böyle Gösteriyor
Kalp krizi, ölüme neden olan en önemli rahatsızlıklardan biridir. İyi haber ise…
Göğüs Kanserinin Vücudunuzda Büyüdüğünü Önceden Anlayabileceğiniz 5 Belirti
Hanımlar, kanser bugünün en ölümcül hastalıklardan biri ve her yıl milyonlarca insanın…
Bu Tariften 2 Yemek Kaşığı Tüketerek Belinizi İnceltin!
Bugüne kadar, doğa herkes için çeşitli ilaçların temel kaynağıydı. İnsanın yaşaması için…
Böbreklerinizde Sorun Olduğunu Gösteren 8 Önemli Belirti
Böbrek bu ihmale gelmez sevgili dostlar. Bu 8 belirtiyi göz önünde bulundurarak…
Jel Oda Kokusu Nasıl Yapılır?
Eğer bulunduğunuz ortamın havasını tazelemek istiyorsanız bu tarif tam size göre. Sizlerle…
Hiç Bir Şey Komşumun Verdiği Tarif Kadar Dişlerimi Beyazlatmadı
Bembeyaz dişlerle gülümsek her insanın hayalidir. Ne yazık ki, hepimizin dişleri doğuştan…
Uyandığınız Anda Yiyin Sizde Herkes Gibi Kilo Verin
Bazı besinleri sabah uyandığınız zaman tüketirseniz hızlı bir şekilde kilo vermeniz kolaylaşacaktır.…